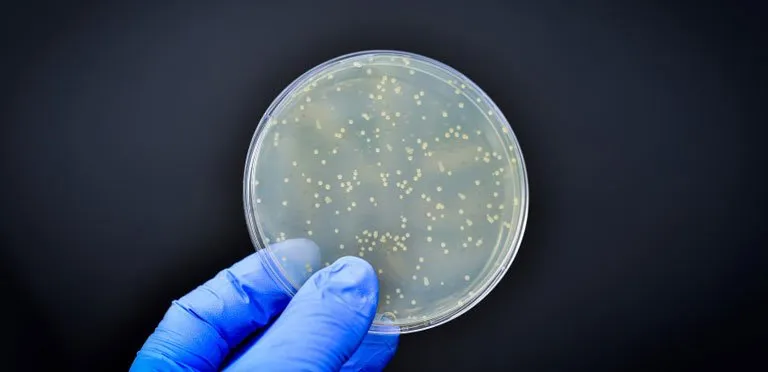
ارزیابی مواد فوم مشبک پلی یورتان به عنوان فیلتر هوا در برابر آلودگی قارچی 🍄

فیلترهای فعلی هوای مورد استفاده در تجهیزات پردازش یا نگهداری مواد غذایی، گران قیمت و یکبار مصرف هستند. توانایی استفاده از فوم پلی یورتان به عنوان فیلتر هوا در برابر آلودگی های قارچی، مفید خواهد بود، زیرا هم ارزان و هم قابل استفاده مجدد هستند. هاگ های قارچی بسیار مقاوم، در همه محیط ها از جمله هوای داخل ساختمان ها و تاسیسات یافت می شوند. اگرچه قارچ ها قادر به ایجاد اثرات نامطلوب جدی نیستند، آن ها می توانند به ساختمان ها آسیب رسانده، باعث فاسد شدن برخی از مواد غذایی در انبارهای مواد غذایی شده و ممکن است باعث ایجاد بیماری های آلرژیک تنفسی در افراد شوند. راه های مختلفی وجود دارد که با آن می توان بیوآئروسل ها را کنترل کرد. این روش ها شامل تابش میکروب کش فرابنفش (UVGI)، یونیزاسیون هوا، تخلیه سد دی الکتریک و غیره است. متداول ترین وسیله برای حذف بیوآئروسل ها از محیط داخلی تأسیسات، فیلتر کردن هوا است.
سیستمهای فیلتر هوا برای انواع مختلف محیطهای محافظتشده، مانند تجهیزات پزشکی، فرآوری مواد غذایی و در محیطهای نگهداری مواد غذایی مهم هستند. رایج ترین سیستم های تصفیه هوا برای کاهش فراوانی قارچ ها در محیط های محافظت شده (به ویژه در بخش های پزشکی) فیلترهای ذرات هوا با کارایی بالا (HEPA ) هستند. مطالعات نشان داده است که قارچ در محیطهایی که فاقد سیستم تصفیه هوا هستند، بسیار بیشتر از محیطهایی یافت می شوند که دارای سیستمهای تصفیه هوای کارآمد و مؤثر هستند. برای اینکه این موضوع درست باشد، سیستم های فیلتر هوا باید به طور مناسب نگهداری شده و در صورت لزوم جایگزین شوند تا از بهترین کیفیت فیلتر اطمینان حاصل شود. در واقع، شیوع بیماری، به دلیل بی توجهی به خطاها و سیستم های تصفیه هوای آلوده غیر معمول است. اهمیت عملکرد بهینه سیستم های تصفیه هوا به محیط های پزشکی محدود نمی شود. کیفیت و کمیت هوا در تاسیسات تولید و نگهداری مواد غذایی به گونه ای تنظیم می شود که از رشد ارگانیسم های قارچی جلوگیری نماید که در غیر این صورت باعث فساد شدید مواد غذایی، به ویژه غلات، آرد، آجیل، پنیرها و میوه ها می شود. نگرانی اصلی آلودگی قارچی مواد غذایی، تولید مایکوتوکسینها بوده، که سمومی هستند که توسط ارگانیسمهای قارچی سمی در محدودههای دما و رطوبت نسبی معین تولید میشوند. دوام و مقاومت در برابر حرارت این سموم، از بین بردن آن ها را بسیار دشوار کرده زیرا با روش های معمول پخت و پز مانند سرخ کردن و جوشاندن از بین نمی روند. در صورت مصرف، مواد غذایی آلوده به مایکوتوکسین ها می توانند باعث ایجاد انواع اختلالات حاد و مزمن در انسان و حیوانات شوند. در نتیجه تلاش های قابل توجهی برای جلوگیری از آلودگی مواد غذایی توسط موجودات قارچی صورت می گیرد. تنظیم هوا معمولاً توسط فیلتراسیون انجام می شود، که میکروارگانیسم های بالقوه مضر را از هوای وارد شده به تاسیسات با گرفتن و نگه داشتن آن ها در محیط فیلتر حذف می کند. آلودگی های قارچی ممکن است از طریق زهکشی ها، دریچه ها، تونل های ضدعفونی، منابع هوای فشرده، مواد خام، بسته بندی، افراد در حال جابجایی و طراحی ضعیف و نگهداری غلط سیستم های تصفیه هوا و غیره وارد تأسیسات تولید و نگهداری مواد غذایی شوند. سیستم های تصفیه هوای کارآمد برای توزیع هوای کاملاً مطبوع در صورت نیاز با نرخ دلخواه طراحی شده اند. سیستم های انتقال هوا باید نه تنها بتوانند میکروارگانیسم های آلوده کننده را از طریق فیلتراسیون از هوا حذف کنند، بلکه بتوانند رشد میکروارگانیسم ها را کاهش داده یا از ورود آن ها جلوگیری کرده، آلودگی متقاطع را محدود و بیوآئروسل ها را از مواد غذایی دور کنند. سیستم ها باید به گونه ای طراحی شوند که امکان انجام تعمیر و نگهداری فیلتر را فراهم کنند. عدم نگهداری مناسب ممکن است منجر به تبدیل شدن خود فیلتر به منبع آلودگی شود که به عنوان یک خطر بزرگ برای سلامتی انسان در بیمارستان ها شناخته می شود.
مطالعه بیشتر: دی ایزوسیانات
پلی یورتان یک پلیمر مصنوعی است که از واکنش یک پلی ال (یک الکل با زنجیره بلند) با یک دی ایزوسیانات تشکیل می شود. بسته به نوع پلی ال مورد استفاده می توان انواع مختلفی از پلی یورتان را تشکیل داد. نوع مشبک فوم پلی یورتان یک نوع فوم متخلخل و کم چگالی است که با ساختار اسکلتی سه بعدی فاقد غشاء بین رشته ها مشخص می شود. تخلخل فوم معمولاً ۹۵٪ بوده اما می تواند تا ۹۸٪ نیز باشد. فوم مشبک در حال حاضر در فیلترهای آب و فیلترهای هوای موجود در واحدهای تهویه مطبوع استفاده می شود. هیچ مطالعه قبلی به اندازه کافی پتانسیل واقعی فوم پلی یورتان مشبک را به عنوان فیلتر هوا در برابر آلودگی های قارچی ارزیابی نکرده است.
بسیاری از مواد فومی به طور قابل توجهی در کاهش تعداد آلودگی قارچی در هوای فیلتر شده موثر هستند. روند واضحی در شکل ۱ قابل مشاهده است که به موجب آن بازده فیلتراسیون فوم های پلی یورتان معمولی با افزایش PPI و ضخامت فوم افزایش می یابد. افزایش PPI منجر به (۱) اندازه منافذ کوچکتر، (۲) مقدار بیشتر منافذ می شود که همه به فرآیند فیلتراسیون کمک می کنند. بررسیها نشان میدهد که اندازه منافذ معمولاً بر راندمان فیلتراسیون اولیه و نهایی تأثیر میگذارد.
هنگامی که PPI فوم معمولی و ضخامت را با کارایی مواد فوم مرتبط میکنیم، PPI دو برابر بیشتر از ضخامت در تعیین راندمان فیلتراسیون مواد فوم تاثیرگذار است. افزایش PPI منجر به ایجاد سلول های بیشتر در یک منطقه خاص می گردد. استفاده از فیلتر فوم پلی یورتان به عنوان فیلتر هوا در تجهیزات پردازش و ذخیره مواد غذایی یا بیمارستان ها مستلزم آن است که PPI نسبتاً بالایی داشته باشد. ضخامت لزوما اولویت در طراحی فیلتر نیست. یک فیلتر فوم پلی یورتان معمولی که به خوبی طراحی شده باشد، ابزار فیلتر مفیدی است، همانطور که در حال حاضر از آن در فیلترهای خودرو و سیستم های HVAC استفاده می شود.
برای بررسی محصولات گوناگون پلی یورتانی از سیستم های صنعت خودرویی، ساختمانی و..، به بخش محصولات وب سایت مراجعه کنید.

بدون دیدگاه